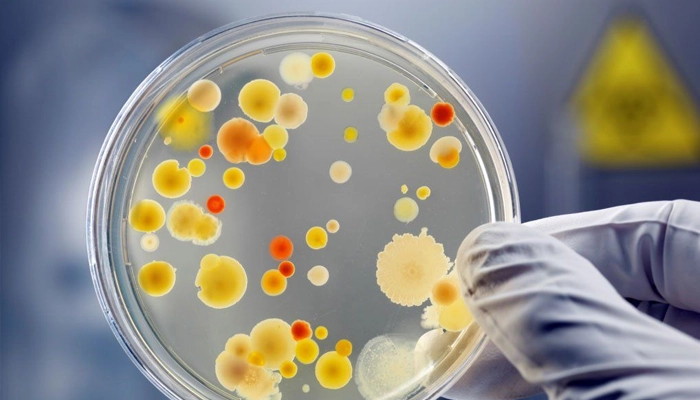

Bệnh Chốc Lở: Nguyên Nhân, Triệu Chứng và Cách Điều Trị
1. Bệnh Chốc Lở Là Gì?
Bệnh chốc lở (impetigo) là bệnh nhiễm trùng da cấp tính do vi khuẩn gây ra, đặc trưng bởi các mụn nước, mụn mủ nông ngoài da, dễ vỡ và đóng vảy màu vàng mật ong đặc trưng. Đây là một trong những bệnh nhiễm trùng da phổ biến nhất ở trẻ em, đặc biệt trong độ tuổi từ 2–10 tuổi, tuy nhiên người lớn hoàn toàn có thể mắc phải — nhất là khi da có sẵn tổn thương hoặc hệ miễn dịch suy giảm.
Bệnh chốc lở lây lan rất nhanh qua tiếp xúc trực tiếp với vùng da tổn thương hoặc qua đồ dùng chung như khăn mặt, quần áo, đồ chơi. Theo thống kê toàn cầu, chốc lở ảnh hưởng đến khoảng 162 triệu trẻ em tại bất kỳ thời điểm nào, đặc biệt phổ biến tại các quốc gia nhiệt đới có khí hậu nóng ẩm như Việt Nam — nơi điều kiện thuận lợi cho vi khuẩn phát triển quanh năm.
Hình ảnh bệnh chốc lở
2. Nguyên Nhân Gây Bệnh Chốc Lở
Bị chốc nguyên nhân do đâu? Dưới đây là nguyên nhân gây bệnh chốc lở:
2.1. Vi khuẩn gây bệnh
Chốc lở do hai loại vi khuẩn chính gây ra:
Staphylococcus aureus (Tụ cầu vàng):
-
Nguyên nhân phổ biến nhất, chiếm trên 80% các ca bệnh hiện nay
-
Gây cả thể chốc lở thông thường lẫn thể bọng nước
-
Đáng lo ngại là sự gia tăng của chủng MRSA (Staphylococcus aureus kháng methicillin) khiến điều trị ngày càng khó khăn hơn
Streptococcus pyogenes (Liên cầu nhóm A — GAS):
-
Gây chủ yếu thể chốc lở không bọng nước
-
Nguy hiểm vì có thể dẫn đến biến chứng viêm cầu thận hậu nhiễm liên cầu nếu không điều trị kịp thời
-
Một số chủng liên cầu độc lực cao có thể gây viêm mô tế bào hoặc nhiễm trùng huyết
2.2. Đường lây truyền
-
Tiếp xúc trực tiếp: Chạm vào vùng da tổn thương của người bệnh
-
Tiếp xúc gián tiếp: Dùng chung khăn, quần áo, đồ chơi, dụng cụ cá nhân
-
Tự lây nhiễm: Người bệnh gãi, chạm vào vùng da lành trên cơ thể mình
2.3. Yếu tố thuận lợi
-
Da bị tổn thương sẵn: vết trầy xước, vết cắn côn trùng, chàm, ghẻ
-
Môi trường nóng ẩm, vệ sinh kém
-
Trẻ em sống đông đúc trong nhà trẻ, trường học
-
Hệ miễn dịch suy giảm, suy dinh dưỡng
-
Tiếp xúc gần với người mang vi khuẩn không có triệu chứng
Vi khuẩn tụ cầu vàng là nguyên nhân phổ biến nhất gây ra bệnh chốc lở
3. Phân Loại và Triệu Chứng Bệnh Chốc Lở
3.1. Chốc lở không bọng nước
Chiếm khoảng 70% các ca bệnh, diễn biến theo trình tự:
-
Giai đoạn khởi phát: Xuất hiện các sẩn đỏ (hồng ban) nhỏ, thường quanh mũi, miệng, tay chân
-
Giai đoạn mụn nước – mụn mủ: Các sẩn nhanh chóng hóa mụn nước trong, rồi đục thành mụn mủ nhỏ
-
Giai đoạn vảy mật ong: Mụn mủ vỡ tạo lớp vảy màu vàng mật ong (honey-colored crust) — dấu hiệu điển hình nhất, dễ nhận biết nhất của chốc lở
-
Ngứa nhẹ, không đau, không sốt hoặc sốt nhẹ trong hầu hết các trường hợp
-
Hạch vùng lân cận có thể sưng nhẹ
3.2. Chốc lở dạng bọng nước
-
Do độc tố exfoliative toxin (ET-A, ET-B) của tụ cầu vàng tiết ra phá vỡ cầu nối desmoglein-1 ở thượng bì
-
Xuất hiện các bọng nước lớn (> 2cm), thành mỏng, chứa dịch trong đến đục, mềm nhão
-
Bọng nước dễ vỡ để lại vết trợt ướt, bờ viền vảy mỏng, không đóng vảy vàng ngay
-
Ít ngứa hoặc đau hơn thể không bọng nước
-
Thường gặp ở thân người, vùng tã lót ở trẻ sơ sinh và nhũ nhi
-
Thể nặng lan toàn thân được gọi là Hội chứng da phỏng rộp do tụ cầu (Staphylococcal Scalded Skin Syndrome — SSSS)
3.3. Chốc loét
-
Là thể chốc lở ăn sâu xuống lớp trung bì, tạo vết loét sâu có vảy dày bám chặt
-
Thường gặp ở chân, đùi, vùng hay bị côn trùng đốt
-
Lành chậm, dễ để lại sẹo
-
Hay gặp ở người suy giảm miễn dịch, suy dinh dưỡng, điều kiện vệ sinh kém
4. Chẩn Đoán Bệnh Chốc Lở
4.1. Chẩn đoán lâm sàng
Hầu hết trường hợp được chẩn đoán dựa trên hình thái tổn thương:
-
Hình thái và màu sắc vảy (vàng mật ong đặc trưng)
-
Vị trí và phân bố tổn thương
-
Tuổi người bệnh và bối cảnh dịch tễ
4.2. Xét nghiệm cận lâm sàng
Không bắt buộc trong các trường hợp điển hình. Được chỉ định khi:
-
Cấy dịch mụn mủ và kháng sinh đồ: Xác định vi khuẩn và độ nhạy kháng sinh — quan trọng khi bệnh nặng, tái phát nhiều lần hoặc nghi ngờ MRSA
-
Tổng phân tích nước tiểu: Tầm soát viêm cầu thận hậu nhiễm liên cầu (đạm niệu, hồng cầu niệu)
-
ASO (Anti-streptolysin O): Xác nhận nhiễm liên cầu nhóm A gần đây
4.3. Chẩn đoán phân biệt
| Bệnh lý | Đặc điểm phân biệt |
|---|---|
| Thủy đậu (Varicella) | Mụn nước toàn thân, sốt cao, các giai đoạn khác nhau đồng thời |
| Herpes simplex | Mụn nước thành chùm, tái phát, vị trí cố định |
| Viêm da tiếp xúc | Liên quan dị nguyên, không có vảy vàng đặc trưng |
| Ghẻ (Scabies) | Ngứa dữ dội về đêm, đường hầm ghẻ, kẽ ngón |
| Nấm da (Tinea) | Tổn thương hình vòng, vảy khô, soi nấm dương tính |
Nuôi cấy vi khuẩn từ tổn thương da là tiêu chuẩn vàng trong chẩn đoán bệnh chốc lở
5. Điều Trị Bệnh Chốc Lở
Nguyên tắc điều trị: Mọi trường hợp chốc lở cần được điều trị bằng kháng sinh — không để tự khỏi — để rút ngắn thời gian bệnh, ngăn lây lan và phòng biến chứng. Lựa chọn kháng sinh tại chỗ hay toàn thân phụ thuộc vào số lượng và diện tích tổn thương.
5.1. Kháng sinh bôi tại chỗ
Ưu tiên cho thể nhẹ, khu trú:
-
Mupirocin (Bactroban) 2%: Bôi 3 lần/ngày trong 5–7 ngày. Hiệu quả cao với cả tụ cầu và liên cầu, ít kháng thuốc — lựa chọn hàng đầu hiện nay
-
Fusidic acid (Fucidin) 2%: Bôi 3 lần/ngày trong 7 ngày, hiệu quả tốt với tụ cầu
-
Retapamulin 1%: Thế hệ mới, bôi 2 lần/ngày trong 5 ngày
Chăm sóc kết hợp:
-
Ngâm và rửa nhẹ vùng tổn thương bằng nước muối sinh lý trước khi bôi thuốc
-
Bóc nhẹ vảy sau khi làm mềm bằng nước ấm, tránh bóc khô gây chảy máu
-
Che phủ vết thương bằng gạc sạch ngăn lây lan
5.2. Kháng sinh toàn thân
Khi tổn thương nhiều (> 5 vị trí), diện rộng, thể bọng nước lan rộng, hoặc không đáp ứng với thuốc bôi sau 3–5 ngày:
-
Amoxicillin-clavulanate (Augmentin): Lựa chọn phổ biến, hiệu quả với cả tụ cầu và liên cầu
-
Cephalexin: Kháng sinh nhóm cephalosporin thế hệ 1, an toàn và hiệu quả
-
Clindamycin: Ưu tiên khi nghi ngờ MRSA hoặc dị ứng penicillin
-
Trimethoprim-sulfamethoxazole (TMP-SMX): Lựa chọn thay thế trong trường hợp MRSA cộng đồng
Quan trọng: Uống đủ liệu trình 7–10 ngày, không tự ý ngừng thuốc dù triệu chứng thuyên giảm sớm — ngừng thuốc sớm là nguyên nhân hàng đầu gây kháng thuốc và tái phát.
Nên đảm bảo tuân thủ điều trị khi mắc bệnh chốc lở.
6. Biến Chứng Nguy Hiểm Của Bệnh Chốc Lở
Chốc lở không điều trị hoặc điều trị không đúng có thể dẫn đến:
-
Viêm mô tế bào (Cellulitis): Nhiễm trùng lan sâu xuống lớp dưới da, gây đỏ, sưng nóng đau lan rộng
-
Viêm cầu thận hậu nhiễm liên cầu (Post-streptococcal glomerulonephritis — PSGN): Xuất hiện 1–3 tuần sau nhiễm liên cầu da, biểu hiện bằng phù nề, tăng huyết áp, tiểu máu — biến chứng nghiêm trọng cần điều trị tại bệnh viện
-
Nhiễm trùng huyết (Septicemia): Hiếm gặp nhưng đe dọa tính mạng
-
Hội chứng SSSS: Lan rộng toàn thân ở trẻ sơ sinh hoặc người suy giảm miễn dịch
7. Phòng Ngừa Bệnh Chốc Lở
-
Rửa tay thường xuyên bằng xà phòng và nước sạch, đặc biệt sau tiếp xúc với người bệnh
-
Không dùng chung khăn mặt, quần áo, đồ chơi với người bệnh
-
Che phủ vết thương bằng gạc sạch khi có tổn thương da hở
-
Cho trẻ nghỉ học cho đến khi điều trị đủ 24–48 giờ và vết thương không còn rỉ dịch
-
Giặt riêng quần áo, chăn ga của người bệnh ở nhiệt độ cao
-
Xử lý ngay các vết trầy xước, vết cắn côn trùng bằng sát khuẩn và băng sạch
-
Tắm rửa hàng ngày, cắt ngắn móng tay cho trẻ tránh gãi gây tổn thương da
8. Khi Nào Cần Gặp Bác Sĩ Ngay?
-
Tổn thương lan rộng nhanh hoặc xuất hiện ở nhiều vị trí đồng thời
-
Sốt cao > 38,5°C, ớn lạnh, mệt mỏi toàn thân
-
Xuất hiện phù nề mặt hoặc chân, tiểu ít, nước tiểu màu đỏ (nghi ngờ viêm cầu thận)
-
Hạch to, đau ở cổ, nách, bẹn
-
Trẻ sơ sinh hoặc trẻ nhỏ dưới 1 tuổi có bất kỳ dấu hiệu nào nghi ngờ chốc lở
-
Không cải thiện sau 3–5 ngày điều trị kháng sinh đúng cách
Việc nhận biết thời điểm cần thăm khám y tế là rất quan trọng để ngăn ngừa biến chứng và hạn chế lây lan.
9. Câu Hỏi Thường Gặp
9.1. Bệnh chốc lở bao lâu thì khỏi?
Với điều trị kháng sinh đúng phác đồ, chốc lở thường cải thiện trong 3–5 ngày và khỏi hoàn toàn sau 7–10 ngày. Nếu không điều trị, bệnh có thể kéo dài 2–3 tuần và tăng nguy cơ lây lan, biến chứng.
9.2. Chốc lở có tự khỏi không?
Một số trường hợp nhẹ có thể tự thuyên giảm sau 2–3 tuần, nhưng không nên chờ đợi vì bệnh lây lan nhanh và có thể gây biến chứng viêm cầu thận. Điều trị kháng sinh giúp rút ngắn thời gian bệnh và ngăn lây cho người xung quanh.
9.3. Trẻ bị chốc lở có cần nghỉ học không?
Có. Trẻ cần nghỉ học cho đến khi điều trị đủ 24–48 giờ và vết thương không còn rỉ dịch hoặc đã đóng vảy hoàn toàn, để tránh lây cho các bạn cùng lớp.
9.4. Chốc lở có để lại sẹo không?
Thể thông thường thường lành không để lại sẹo nếu không gãi. Thể chốc loét (ecthyma) ăn sâu hơn có thể để lại sẹo thâm nhạt màu. Tránh gãi và điều trị sớm giúp giảm nguy cơ sẹo.
9.5. Bị chốc lở kiêng ăn gì?
Khi mắc Bệnh chốc lở, nên hạn chế thực phẩm dễ gây kích ứng và làm chậm lành vết thương như đồ cay nóng, hải sản, thịt gà, đồ nếp, thực phẩm nhiều đường và dầu mỡ; đồng thời tránh rượu bia để giảm nguy cơ viêm nhiễm và sẹo.
9.6. Trẻ bị chốc đầu tắm lá gì?
Trẻ bị chốc đầu có thể tắm hoặc gội bằng các loại lá có tính kháng khuẩn và làm dịu da như lá trà xanh, lá khế, lá ổi hoặc lá neem (sầu đâu), nhưng cần rửa sạch, đun sôi và để nguội trước khi sử dụng để đảm bảo an toàn.
Tổng Kết
Bệnh chốc lở là bệnh nhiễm trùng da phổ biến ở trẻ em, lây lan nhanh nhưng hoàn toàn có thể điều trị khỏi với kháng sinh phù hợp. Nhận biết sớm qua dấu hiệu vảy vàng mật ong đặc trưng, điều trị đúng phác đồ đủ liệu trình và thực hiện biện pháp phòng lây nhiễm là ba yếu tố then chốt kiểm soát bệnh hiệu quả — bảo vệ sức khỏe cho trẻ và cả gia đình.
Nội dung chỉ mang tính giáo dục, không thay thế tư vấn y tế chuyên nghiệp.
Tài liệu tham khảo
-
Hartman-Adams H et al. (2014). Impetigo: Diagnosis and Treatment. American Family Physician
-
Koning S et al. (2012). Interventions for impetigo. Cochrane Database of Systematic Reviews
-
Bộ Y tế Việt Nam – Hướng dẫn chẩn đoán và điều trị các bệnh da liễu
Số lần xem: 72